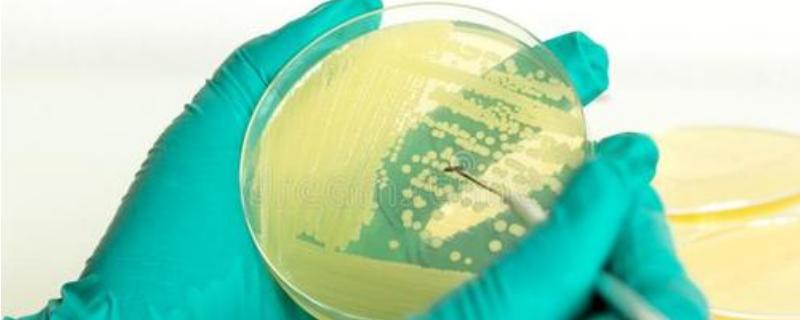

大豆种子哪个品种好
2022-09-16 09:17:04

收玉米掉粒严重怎么办
2022-09-16 08:54:04

大蒜种植前拌什么药
2022-09-16 08:34:01

豪猪的刺能再生吗?有什么作用
2022-09-16 08:19:50

可食用的花卉有哪些
2022-09-15 10:56:10

延吉市有哪些特产
2022-09-15 10:39:18

如何饲养大麦虫
2022-09-15 10:19:48

什么鱼是大头鱼
2022-09-15 10:05:16

北方板栗品种有哪些
2022-09-15 09:47:59

泸州有哪些土特产
2022-09-15 09:29:08

大葱是蒜头还是葱头?如何腌制葱头
2022-09-15 09:12:40

十大特产必购北京
2022-09-15 08:55:18

板栗产量好的品种
2022-09-15 08:39:38

淡水鱼只有一根主刺
2022-09-15 08:28:33

鲈鱼有哪些常见品种
2022-09-14 11:00:35
柑橘是如何使用微生物肥料的
2022-09-14 10:47:19

你认为种植花生时如何控制青虫害
2022-09-14 10:34:27

你认为有什么措施可以增加大蒜的硒含量
2022-09-14 10:15:57

大全常见鲫鱼品种
2022-09-14 10:05:22

吉林临江市有哪些特产
2022-09-14 09:53:15